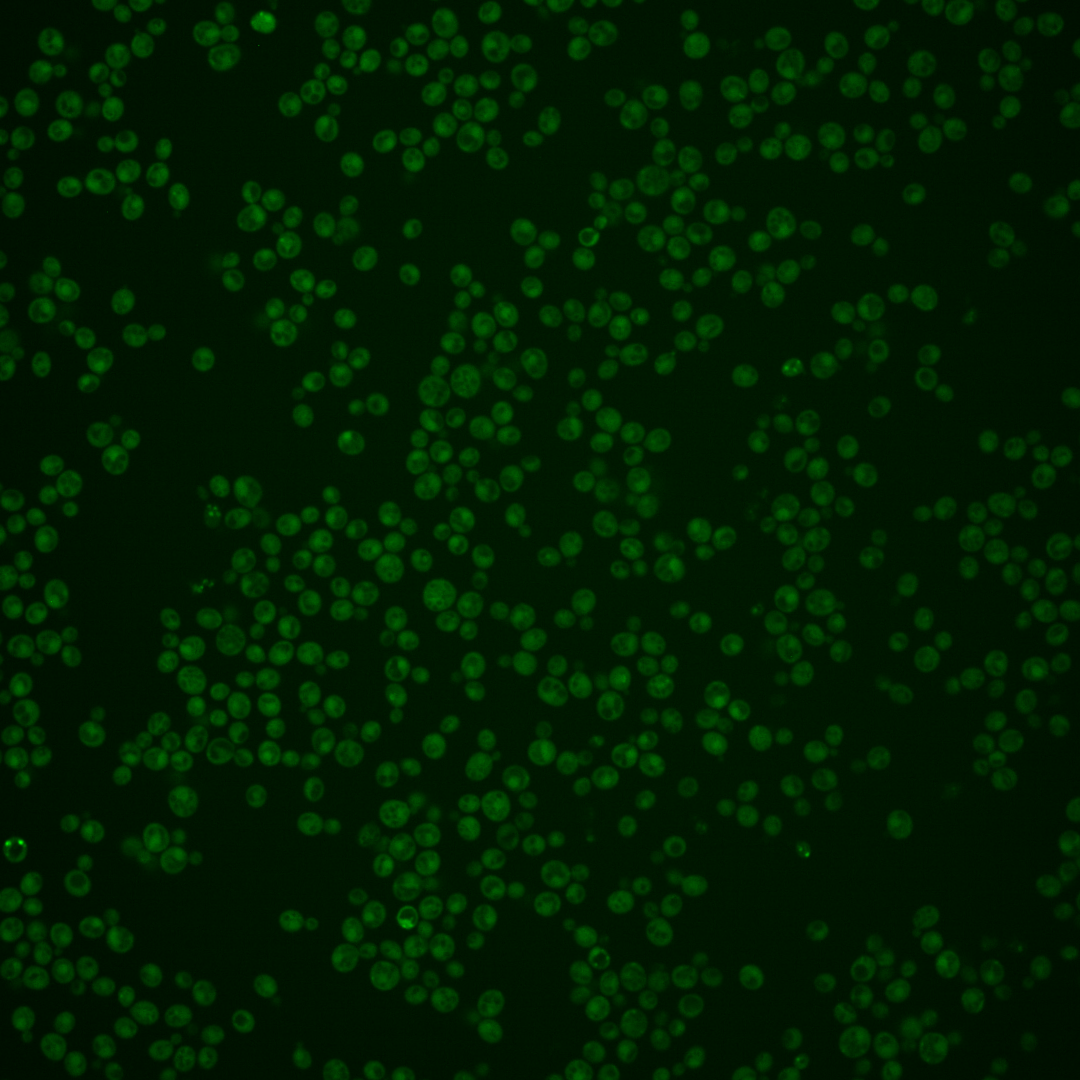
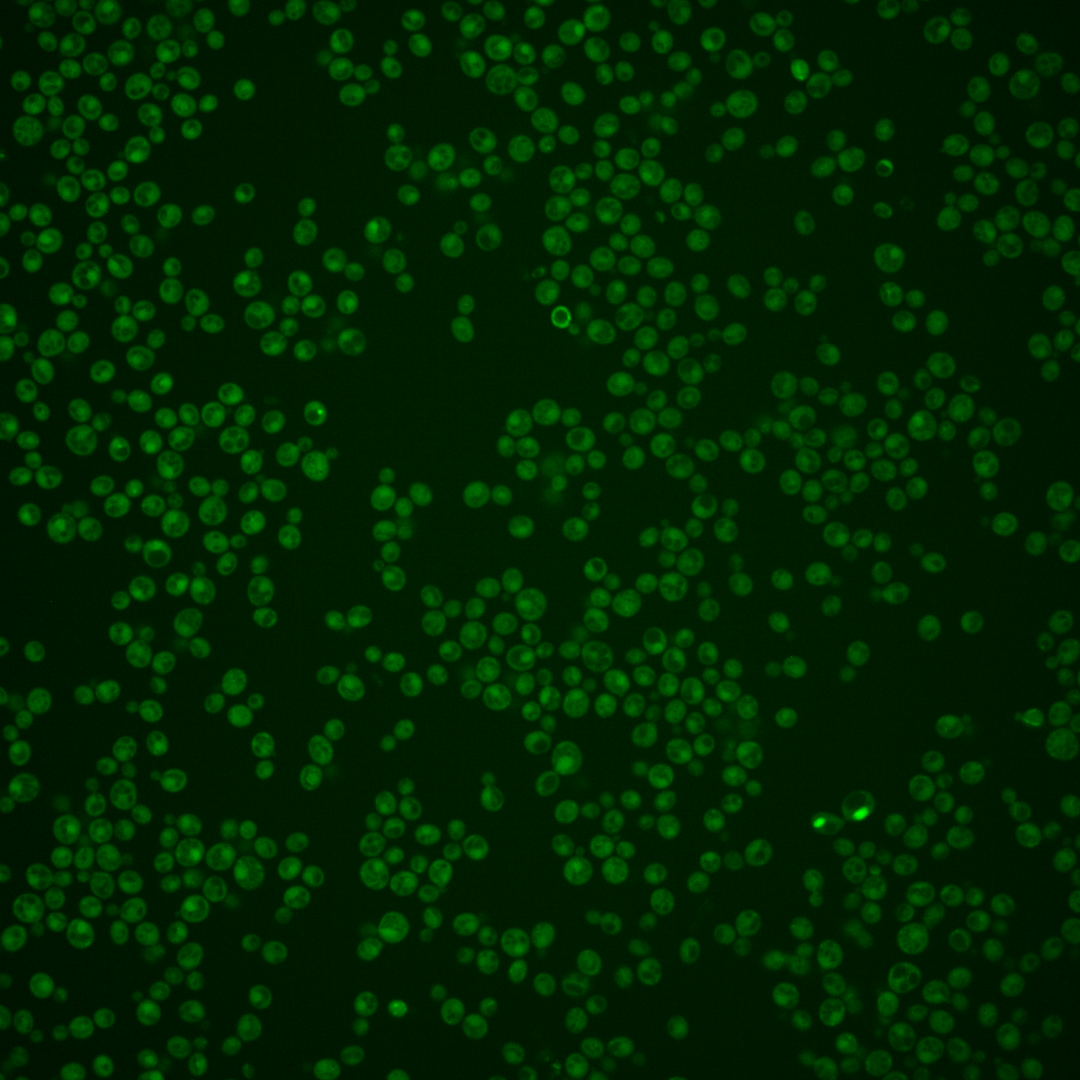

| Standard name | |
|---|---|
| Human Ortholog | |
| Description | Subunit of the Iml1p/SEACIT complex; SEACIT (Iml1p-Npr2p-Npr3p) is a subcomplex of the SEA complex, a coatomer-related complex that associates dynamically with the vacuole; Npr2p may have a structural or regulatory role, supporting Iml1p function as a GAP for the Rag family GTPase Gtr1p, and resulting in inhibition of TORC1 signaling in response to amino acid deprivation; SEACIT is required for non-nitrogen-starvation-induced autophagy; homolog of human tumor suppressor NPRL2 |
Micrographs




















































































Sub-cellular Localization
Yeast GFP Assignment
Protein Abundance
Localization Change
External localization resources
| ensLOC | DeepLoc | |||||||||||||||||||||||
|---|---|---|---|---|---|---|---|---|---|---|---|---|---|---|---|---|---|---|---|---|---|---|---|---|
| Localization | WT1 | WT2 | WT3 | RAP60 | RAP140 | RAP220 | RAP300 | RAP380 | RAP460 | RAP540 | RAP620 | RAP700 | HU80 | HU120 | HU160 | rpd3Δ_1 | rpd3Δ_2 | rpd3Δ_3 | WT1 | WT2 | WT3 | AF100 | AF140 | AF180 |
| Cortical Patches | 0 | 0 | 0 | 1 | 0 | 0 | 1 | 1 | 0 | 2 | 2 | 0 | 0 | 0 | 0 | – | – | – | 0 | 2 | 0 | 0 | 0 | 2 |
| Bud | 0 | 0 | 0 | 1 | 2 | 0 | 1 | 6 | 2 | 6 | 9 | 2 | 0 | 0 | 0 | – | – | – | 0 | 0 | 1 | 0 | 0 | 3 |
| Bud Neck | 0 | 0 | 1 | 1 | 0 | 2 | 3 | 4 | 2 | 6 | 2 | 2 | 0 | 0 | 0 | – | – | – | 0 | 0 | 0 | 0 | 0 | 0 |
| Bud Site | 0 | 0 | 0 | 0 | 0 | 0 | 0 | 0 | 0 | 0 | 0 | 0 | 0 | 0 | 0 | – | – | – | – | – | – | – | – | – |
| Cell Periphery | 0 | 0 | 1 | 0 | 0 | 0 | 1 | 0 | 0 | 3 | 0 | 1 | 0 | 0 | 1 | – | – | – | 0 | 0 | 0 | 0 | 0 | 0 |
| Cytoplasm | 121 | 149 | 63 | 215 | 317 | 296 | 418 | 425 | 170 | 272 | 197 | 334 | 16 | 83 | 154 | – | – | – | 87 | 108 | 30 | 15 | 88 | 122 |
| Endoplasmic Reticulum | 2 | 1 | 0 | 5 | 1 | 1 | 5 | 0 | 0 | 0 | 6 | 1 | 1 | 0 | 0 | – | – | – | 1 | 0 | 1 | 0 | 0 | 0 |
| Endosome | 1 | 9 | 0 | 3 | 8 | 8 | 11 | 11 | 2 | 5 | 0 | 3 | 0 | 2 | 2 | – | – | – | 15 | 27 | 7 | 0 | 5 | 10 |
| Golgi | 0 | 0 | 0 | 1 | 0 | 1 | 0 | 0 | 0 | 0 | 0 | 0 | 0 | 0 | 0 | – | – | – | 1 | 2 | 0 | 0 | 0 | 0 |
| Mitochondria | 8 | 3 | 0 | 0 | 0 | 15 | 47 | 40 | 52 | 40 | 126 | 110 | 0 | 0 | 0 | – | – | – | 19 | 15 | 17 | 1 | 6 | 6 |
| Nucleus | 1 | 1 | 1 | 0 | 0 | 3 | 2 | 2 | 2 | 6 | 1 | 1 | 0 | 0 | 1 | – | – | – | 0 | 0 | 1 | 0 | 0 | 1 |
| Nuclear Periphery | 0 | 1 | 0 | 0 | 0 | 0 | 1 | 0 | 0 | 0 | 0 | 0 | 0 | 0 | 0 | – | – | – | 0 | 0 | 0 | 0 | 1 | 0 |
| Nucleolus | 0 | 0 | 0 | 0 | 0 | 0 | 0 | 0 | 0 | 0 | 0 | 0 | 0 | 0 | 0 | – | – | – | 0 | 0 | 0 | 0 | 0 | 0 |
| Peroxisomes | 0 | 0 | 0 | 1 | 0 | 1 | 0 | 1 | 0 | 0 | 0 | 0 | 0 | 0 | 0 | – | – | – | 0 | 0 | 0 | 0 | 0 | 0 |
| SpindlePole | 1 | 2 | 0 | 3 | 0 | 3 | 6 | 9 | 3 | 7 | 1 | 5 | 0 | 0 | 0 | – | – | – | 2 | 3 | 0 | 0 | 3 | 6 |
| Vac/Vac Membrane | 3 | 21 | 4 | 9 | 46 | 29 | 27 | 15 | 13 | 10 | 10 | 7 | 0 | 0 | 7 | – | – | – | 18 | 33 | 35 | 3 | 20 | 35 |
| Unique Cell Count | 133 | 175 | 66 | 229 | 356 | 340 | 475 | 479 | 207 | 326 | 287 | 400 | 17 | 85 | 162 | 152 | 200 | 100 | 24 | 130 | 195 | |||
| Labelled Cell Count | 137 | 187 | 70 | 240 | 374 | 359 | 523 | 514 | 246 | 357 | 354 | 466 | 17 | 85 | 165 | 152 | 200 | 100 | 24 | 130 | 195 | |||
Yeast GFP Assignment
Protein Abundance
| Screen | WT1 | WT2 | WT3 | RAP60 | RAP140 | RAP220 | RAP300 | RAP380 | RAP460 | RAP540 | RAP620 | RAP700 | HU80 | HU120 | HU160 | rpd3Δ_1 | rpd3Δ_2 | rpd3Δ_3 | AF100 | AF140 | AF180 |
|---|---|---|---|---|---|---|---|---|---|---|---|---|---|---|---|---|---|---|---|---|---|
| Mean Cell GFP Intensity (1e-4) | 3.6 | 4.7 | 5.5 | 5.2 | 5.9 | 4.8 | 4.8 | 5.0 | 4.1 | 4.2 | 3.9 | 4.2 | 4.5 | 5.4 | 5.2 | – | – | – | – | 4.8 | 5.4 |
| Std Deviation (1e-4) | 0.6 | 1.2 | 1.3 | 1.2 | 1.8 | 1.4 | 1.3 | 1.2 | 1.3 | 0.9 | 1.0 | 1.3 | 0.7 | 1.1 | 1.2 | – | – | – | – | 1.1 | 1.2 |
| Intensity Change (Log2) | – | – | – | -0.09 | 0.1 | -0.2 | -0.2 | -0.13 | -0.42 | -0.38 | -0.52 | -0.39 | -0.3 | -0.04 | -0.09 | – | – | – | – | -0.2 | -0.04 |
Localization Change
| Localization | RAP60 | RAP140 | RAP220 | RAP300 | RAP380 | RAP460 | RAP540 | RAP620 | RAP700 | HU80 | HU120 | HU160 | rpd3Δ_1 | rpd3Δ_2 | rpd3Δ_3 |
|---|---|---|---|---|---|---|---|---|---|---|---|---|---|---|---|
| Actin | – | – | – | – | – | – | – | – | – | – | – | – | – | – | – |
| Bud | – | – | – | – | – | – | – | – | – | – | – | – | – | – | – |
| Bud Neck | – | – | – | – | – | – | – | – | – | – | – | – | – | – | – |
| Bud Site | – | – | – | – | – | – | – | – | – | – | – | – | – | – | – |
| Cell Periphery | – | – | – | – | – | – | – | – | – | – | – | – | – | – | – |
| Cyto | – | – | – | – | – | – | – | – | – | – | – | – | – | – | – |
| Endoplasmic Reticulum | – | – | – | – | – | – | – | – | – | – | – | – | – | – | – |
| Endosome | – | – | – | – | – | – | – | – | – | – | – | – | – | – | – |
| Golgi | – | – | – | – | – | – | – | – | – | – | – | – | – | – | – |
| Mitochondria | – | – | – | – | – | – | – | – | – | – | – | – | – | – | – |
| Nuclear Periphery | – | – | – | – | – | – | – | – | – | – | – | – | – | – | – |
| Nuc | – | – | – | – | – | – | – | – | – | – | – | – | – | – | – |
| Nucleolus | – | – | – | – | – | – | – | – | – | – | – | – | – | – | – |
| Peroxisomes | – | – | – | – | – | – | – | – | – | – | – | – | – | – | – |
| SpindlePole | – | – | – | – | – | – | – | – | – | – | – | – | – | – | – |
| Vac | – | – | – | – | – | – | – | – | – | – | – | – | – | – | – |
| Cortical Patches | – | – | – | – | – | – | – | – | – | – | – | – | – | – | – |
| Cytoplasm | – | – | – | – | – | – | – | – | – | – | – | – | – | – | – |
| Nucleus | – | – | – | – | – | – | – | – | – | – | – | – | – | – | – |
| Vacuole | – | – | – | – | – | – | – | – | – | – | – | – | – | – | – |
External localization resources
Images






























Protein Concentration and Protein Localization Data
| R1 | R2 | R3 | ||||||||||||||||
|---|---|---|---|---|---|---|---|---|---|---|---|---|---|---|---|---|---|---|
| G1 Pre-START | G1 Post-START | S/G2 | Metaphase | Anaphase | Telophase | G1 Pre-START | G1 Post-START | S/G2 | Metaphase | Anaphase | Telophase | G1 Pre-START | G1 Post-START | S/G2 | Metaphase | Anaphase | Telophase | |
| Concentration | 0.0463 | 0.2101 | 0.1766 | -0.0907 | 0.3437 | -0.1217 | -0.0479 | 0.6919 | 0.4591 | 0.6426 | 0.7838 | 0.1467 | -1.3362 | -1.0193 | -1.1813 | -0.9332 | -0.9202 | -1.2982 |
| Actin | 0.0258 | 0.001 | 0.0362 | 0.0013 | 0.0428 | 0.0235 | 0.0205 | 0.0009 | 0.0014 | 0.0354 | 0.0267 | 0.0088 | 0.0332 | 0.0001 | 0.0072 | 0.0002 | 0.0074 | 0.0024 |
| Bud | 0.0004 | 0.0031 | 0.0027 | 0.0019 | 0.0049 | 0.0009 | 0.0008 | 0.0003 | 0.0002 | 0.0017 | 0.0009 | 0.0013 | 0.001 | 0.0002 | 0.0015 | 0.0002 | 0.0004 | 0.0035 |
| Bud Neck | 0.0175 | 0.0007 | 0.0016 | 0.0003 | 0.0034 | 0.0006 | 0.0016 | 0.0001 | 0.0001 | 0.0002 | 0.0006 | 0.0012 | 0.0032 | 0.0001 | 0.0006 | 0.0001 | 0.0003 | 0.002 |
| Bud Periphery | 0.0007 | 0.0087 | 0.0042 | 0.0014 | 0.0084 | 0.0054 | 0.0017 | 0.0003 | 0.0002 | 0.0014 | 0.002 | 0.0031 | 0.002 | 0.0002 | 0.0017 | 0.0001 | 0.0005 | 0.0035 |
| Bud Site | 0.0052 | 0.0072 | 0.0146 | 0.0007 | 0.0519 | 0.0002 | 0.0094 | 0.001 | 0.0004 | 0.0078 | 0.0009 | 0.0005 | 0.0071 | 0.0005 | 0.0097 | 0 | 0.0004 | 0.0099 |
| Cell Periphery | 0.0004 | 0.0004 | 0.0009 | 0.0003 | 0.0024 | 0.0003 | 0.0006 | 0.0002 | 0.0001 | 0.0001 | 0.0002 | 0.0002 | 0.0006 | 0.0001 | 0.0002 | 0.0001 | 0.0001 | 0.0005 |
| Cytoplasm | 0.1276 | 0.2204 | 0.1896 | 0.3533 | 0.2042 | 0.3515 | 0.1684 | 0.347 | 0.2992 | 0.2289 | 0.0655 | 0.3938 | 0.1335 | 0.3381 | 0.2201 | 0.1597 | 0.2141 | 0.2978 |
| Cytoplasmic Foci | 0.0815 | 0.0264 | 0.048 | 0.0267 | 0.0923 | 0.04 | 0.0367 | 0.0313 | 0.0298 | 0.0205 | 0.0541 | 0.0329 | 0.0603 | 0.0456 | 0.0369 | 0.0535 | 0.0318 | 0.0405 |
| Eisosomes | 0.0007 | 0.0002 | 0.0006 | 0.0006 | 0.0006 | 0.0007 | 0.0003 | 0.0001 | 0.0001 | 0.0001 | 0.0002 | 0.0001 | 0.0009 | 0.0001 | 0.0002 | 0.0002 | 0.0001 | 0.0005 |
| Endoplasmic Reticulum | 0.0155 | 0.006 | 0.0053 | 0.0056 | 0.0042 | 0.0056 | 0.006 | 0.0041 | 0.0077 | 0.0007 | 0.0019 | 0.0036 | 0.0055 | 0.0025 | 0.0022 | 0.0007 | 0.0036 | 0.0044 |
| Endosome | 0.0394 | 0.0499 | 0.0529 | 0.0577 | 0.0669 | 0.0619 | 0.0576 | 0.0766 | 0.0772 | 0.0887 | 0.2139 | 0.0881 | 0.0477 | 0.0497 | 0.0459 | 0.0869 | 0.1334 | 0.0844 |
| Golgi | 0.0157 | 0.0026 | 0.0201 | 0.0096 | 0.0631 | 0.01 | 0.012 | 0.0018 | 0.0028 | 0.0052 | 0.1088 | 0.0056 | 0.0132 | 0.0014 | 0.0082 | 0.0004 | 0.0378 | 0.0052 |
| Lipid Particles | 0.0381 | 0.0034 | 0.0081 | 0.0034 | 0.0322 | 0.0054 | 0.0255 | 0.0034 | 0.0033 | 0.0201 | 0.025 | 0.0024 | 0.0214 | 0.0051 | 0.01 | 0.0024 | 0.0156 | 0.0031 |
| Mitochondria | 0.0036 | 0.0024 | 0.0456 | 0.0027 | 0.0829 | 0.0264 | 0.006 | 0.0023 | 0.0117 | 0.0112 | 0.0312 | 0.0303 | 0.0216 | 0.0015 | 0.0143 | 0.0008 | 0.0162 | 0.0278 |
| None | 0.5312 | 0.6205 | 0.5264 | 0.5019 | 0.2683 | 0.4341 | 0.6151 | 0.4725 | 0.5192 | 0.5446 | 0.4277 | 0.3797 | 0.6013 | 0.5183 | 0.6111 | 0.6359 | 0.3844 | 0.4821 |
| Nuclear Periphery | 0.0069 | 0.0038 | 0.0059 | 0.0058 | 0.0049 | 0.0027 | 0.0073 | 0.002 | 0.0051 | 0.001 | 0.0015 | 0.0025 | 0.0095 | 0.0013 | 0.0028 | 0.0009 | 0.0319 | 0.0022 |
| Nucleolus | 0.0019 | 0.0051 | 0.0004 | 0.0004 | 0.0029 | 0.0005 | 0.0013 | 0.0003 | 0.0003 | 0.0002 | 0.0002 | 0.0002 | 0.0009 | 0.0003 | 0.0006 | 0.0004 | 0.0019 | 0.0004 |
| Nucleus | 0.0041 | 0.0024 | 0.0024 | 0.0049 | 0.0028 | 0.0024 | 0.0035 | 0.0016 | 0.0031 | 0.0006 | 0.0009 | 0.0013 | 0.0018 | 0.0012 | 0.0013 | 0.0023 | 0.0078 | 0.0025 |
| Peroxisomes | 0.0525 | 0.001 | 0.0088 | 0.0005 | 0.0075 | 0.0031 | 0.0068 | 0.0102 | 0.0005 | 0.0036 | 0.0169 | 0.0141 | 0.0164 | 0.0061 | 0.01 | 0.0003 | 0.023 | 0.0009 |
| Punctate Nuclear | 0.0081 | 0.0018 | 0.0024 | 0.0022 | 0.01 | 0.0016 | 0.0052 | 0.0009 | 0.0009 | 0.0004 | 0.0007 | 0.0005 | 0.0067 | 0.0028 | 0.0012 | 0.0004 | 0.0052 | 0.0014 |
| Vacuole | 0.0213 | 0.0299 | 0.0186 | 0.0143 | 0.0364 | 0.0192 | 0.0119 | 0.0362 | 0.0286 | 0.0216 | 0.0163 | 0.0242 | 0.0094 | 0.0227 | 0.0113 | 0.0465 | 0.0747 | 0.0211 |
| Vacuole Periphery | 0.0016 | 0.0032 | 0.0046 | 0.0045 | 0.0069 | 0.0042 | 0.0019 | 0.007 | 0.0083 | 0.0063 | 0.0039 | 0.0058 | 0.0027 | 0.0022 | 0.0029 | 0.0081 | 0.0096 | 0.004 |
Sequencing Data
| R1 | R2 | |||||||||
|---|---|---|---|---|---|---|---|---|---|---|
| G1 Post-START | S/G2 | Metaphase | Anaphase | Telophase | G1 Post-START | S/G2 | Metaphase | Anaphase | Telophase | |
| Gene Expression | 9.5533 | 6.9388 | 8.7135 | 14.5639 | 5.419 | 12.5317 | 10.5237 | 12.9307 | 12.3587 | 14.1577 |
| Translational Efficiency | 0.6598 | 0.5394 | 0.611 | 0.3435 | 0.8391 | 0.3798 | 0.6205 | 0.4862 | 0.553 | 0.4872 |
Hit Data
| Dataset | Hit |
|---|---|
| Protein Concentration | ✔ |
| Protein Localization | ✘ |
| Gene Expression | ✘ |
| Translational Efficiency | ✘ |
Endocytosis
| Temp | Actin Patch (Sac6-tdTomato) | Cortical Patch (Sla1-GFP) | Late Endosome (Snf7-GFP) | Vacuole (Vph1-GFP) |
|---|---|---|---|---|
| 37℃ | ||||
| RT |
Cell Cycle Omics
CYCLoPs (Npr2-GFP)
| Gene / Allele | Actin Patch (Sac6-tdTomato) | Cortical Patch (Sla1-GFP) | Late Endosome (Snf7-GFP) | Vacuole (Sac6-tdTomato) |
|---|
| Gene | Images |
|---|
| Gene | Images |
|---|
Images are not yet available
Images are not yet available